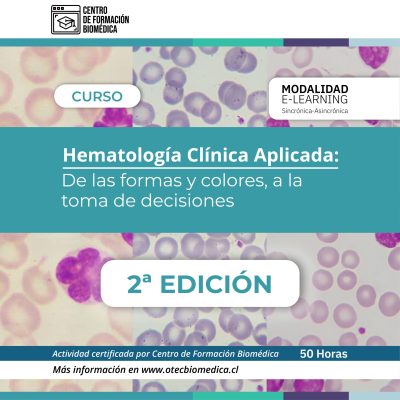
Hematología 01

Cursos y Webinars Disponibles
$119.990 El precio original era: $119.990.$71.990El precio actual es: $71.990.
$99.990 El precio original era: $99.990.$69.990El precio actual es: $69.990.
$80.000 El precio original era: $80.000.$47.990El precio actual es: $47.990.
$99.990 El precio original era: $99.990.$79.990El precio actual es: $79.990.
$80.000 El precio original era: $80.000.$59.990El precio actual es: $59.990.
$180.000 El precio original era: $180.000.$119.990El precio actual es: $119.990.
$80.000 El precio original era: $80.000.$69.990El precio actual es: $69.990.
$180.000 El precio original era: $180.000.$140.000El precio actual es: $140.000.
$99.990 El precio original era: $99.990.$64.990El precio actual es: $64.990.
$159.990 El precio original era: $159.990.$95.994El precio actual es: $95.994.
$319.980 El precio original era: $319.980.$239.990El precio actual es: $239.990.
$119.990 El precio original era: $119.990.$71.990El precio actual es: $71.990.
$99.990 El precio original era: $99.990.$69.990El precio actual es: $69.990.
$80.000 El precio original era: $80.000.$47.990El precio actual es: $47.990.
$99.990 El precio original era: $99.990.$79.990El precio actual es: $79.990.
$80.000 El precio original era: $80.000.$59.990El precio actual es: $59.990.
$180.000 El precio original era: $180.000.$119.990El precio actual es: $119.990.
$80.000 El precio original era: $80.000.$69.990El precio actual es: $69.990.
$180.000 El precio original era: $180.000.$140.000El precio actual es: $140.000.
$99.990 El precio original era: $99.990.$64.990El precio actual es: $64.990.
$159.990 El precio original era: $159.990.$95.994El precio actual es: $95.994.
$319.980 El precio original era: $319.980.$239.990El precio actual es: $239.990.

![[BROCHURE] Acreditación Anatomía Patológica-10 [BROCHURE] Acreditación Anatomía Patológica-10](https://otecbiomedica.cl/wp-content/uploads/elementor/thumbs/BROCHURE-Acreditacion-Anatomia-Patologica-10-scaled-rm7ca3y2wwoo30wu6k97hnmwb6altxyumk12bmvcm8.jpg)



![[BROCHURE] Inmunohematología-09 [BROCHURE] Inmunohematología-09](https://otecbiomedica.cl/wp-content/uploads/elementor/thumbs/BROCHURE-Inmunohematologia-09-rm7ca3y2wwoo30wu6k97hnmwb6altxyumk12bmvcm8.jpg)














